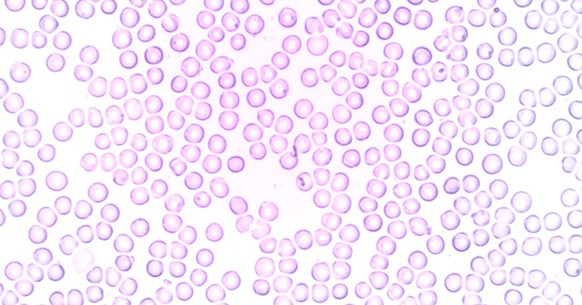

I globuli bianchi sono delle importantissime cellule del sangue, deputate alla difesa dell’organismo e alla risposta immunitaria agli agenti esteri. Noti anche come leucociti, agiscono riconoscendo e sopprimendo batteri e virus che potrebbero aver avuto accesso al corpo, bloccando così sul nascere le principali infezioni. Ma cosa accade quando la loro concentrazione nel sangue è troppo bassa e come riportare questi livelli alla normalità?
Globuli bianchi: a cosa servono e livelli normali
Così come già accennato, i globuli bianchi sono delle importanti cellule della porzione corpuscolata del sangue. Vengono prodotti dal midollo osseo e, quando maturi, si distribuiscono in tutti gli organi grazie al circolo sanguigno. La loro funzione principale è proteggere l’organismo dagli agenti esterni: la loro azione congiunta determina il sistema immunitario di un individuo.
Leucociti: tipologie e funzioni

I leucociti comprendono diverse tipologie di cellule, precisamente linfociti, monociti e granulociti, questi ultimi suddivisi in neutrofili, eosinofili e basofili. Tutte queste cellule assolvono principalmente a due compiti:
- Garantire l’immunità innata: si tratta della funzione di contrasto aspecifica agli agenti esterni penetrati nell’organismo, di cui gli uomini dispongono sin dalla nascita, ed è esercitata soprattutto da granulociti e monociti;
- Garantire l’immunità acquisita: è quel tipo di protezione che si forma nel tempo, in seguito all’esposizione ad agenti infettivi o alle vaccinazioni. L’organismo impara a riconoscere virus e batteri dannosi e ne elabora un contrasto specifico, fornito dai linfociti.
Concentrazione ematica e livelli standard

La concentrazione ematica dei leucociti viene valutata sottoponendosi a un comune emocromo, ovvero un’analisi del sangue che restituisce una rosa di parametri fondamentali per verificare lo stato di salute di un individuo.
I livelli standard di globuli bianchi, seppure con alcune disparità relative all’età e al genere sessuale, non dovrebbero essere inferiori alle 3.500 unità per microlitro di sangue. Quando il valore scende al di sotto di questa soglia si verifica una leucopenia, un’insufficienza di globuli bianchi, che può portare a conseguenze anche serie.
Cause e sintomi dei globuli bianchi bassi
Le cause di una leucopenia, ovvero di una riduzione dei livelli normali di globuli bianchi, possono essere le più disparate. Dalla semplice diminuzione dovuta a un periodo particolarmente stressante fino a patologie gravi, è necessario sempre affidarsi al medico per capire le ragioni di questa riduzione.
Cosa abbassa i globuli bianchi

Fra le ragioni che possono portare a un abbassamento dei globuli bianchi nel sangue, vi possono essere:
- malattie autoimmuni;
- tumori;
- infezioni batteriche e virali;
- anemia aplastica;
- deficit vitaminici, in particolare relativi alla vitamina B12;
- carenza di zinco;
- alcolismo;
- assunzione prolungata di farmaci;
- terapie mediche come la chemioterapia e la radioterapia.
Anche lo stile di vita può influire, andando a ledere le normali difese immunitarie dell’organismo. Ad esempio, un’alimentazione sregolata e priva di tutti i nutrienti di cui l’organismo ha bisogno – in particolare vitamine e amminoacidi essenziali – può ridurre la produzione di nuovi leucociti.
Ancora, possono avere un peso il fumo di sigaretta, la mancanza di allenamento fisico, la sedentarietà eccessiva e problematiche croniche a livello gastrointestinale.
Sintomi della carenza di leucociti

La leucopenia può manifestarsi con vari sintomi, creando una serie di disagi e malesseri che non devono essere trascurati. È possibile avvertire debolezza, vertigini, mal di testa e dolori ossei, ma anche mostrare pallore. Può verificarsi una perdita di peso immotivata e spesso si è soggetti maggiormente all’attacco di virus e agenti infettivi. Questo proprio perché le difese immunitarie non sono in grado di rappresentare una barriera sufficientemente forte.
Fra i segnali da tenere sotto controllo e da riferire al medico, vi sono:
- Febbre persistente;
- Stanchezza eccessiva e prolungata anche per settimane;
- Emicrania frequente;
- Nausea, vomito e malessere generale;
- Disturbi digestivi;
- Problemi al fegato e alla milza;
- Disturbi respiratori;
- Ulcere orali;
- Dermatiti e altri problemi della pelle.
Globuli bianchi bassi, cosa mangiare

Per i globuli bianchi bassi l’alimentazione può influire in modo notevole, specialmente se si cerca di integrare cibi che contengono vitamine e sali minerali indispensabili per rinforzare il sistema immunitario. Appartengono a questa categoria:
- agrumi: sono frutti come le arance, i limoni e i mandarini, ricchissimi di vitamina C, fondamentale per fissare il ferro nel sangue e per potenziare le difese immunitarie;
- ginseng: questa radice orientale viene considerata un ottimo immunostimolante e antiossidante naturale;
- tè nero: questa bevanda contiene teanina, aminoacido molto potente contro i radicali liberi;
- aglio: per quanto possa sembrare indigesto, favorisce il proliferare delle cellule in grado di contrastare le infezioni che colpiscono l’organismo;
- fermenti lattici: riequilibrando la flora batteria possono aiutare il sistema immunitario;
- pesce: quello azzurro, che comprende tonno, sardine, sgombri, è un’ottima fonte di vitamina B;
- echinacea: questa pianta, dalla quale si ottengono preziosi infusi e tisane, rappresenta un toccasana per stimolare le difese immunitarie e per migliorare la capacità dei globuli bianchi di combattere contro virus e batteri e virus;
- carote: il betacarotene contenuto in questi ortaggi è in grado di fare aumentare il numero delle cellule chiamate a combattere le infezioni.
Leucopenia: quali cibi evitare

Vi sono poi degli alimenti che si dovrebbero evitare in caso di accertata leucopenia, poiché potrebbero esporre un organismo debilitato ad agenti esterni – per quanto comuni e normalmente innocui – che non sarebbe in grado di affrontare. Aumentando così il rischio di sviluppare infezioni, rendendo difficile la guarigione.
Andrebbero eliminati oppure limitati fino a completo recupero delle funzionalità del sistema immunitario:
- Pesce, carne e uova crude o poco cotte;
- Latte crudo e succhi di frutta non pastorizzati;
- Formaggi con muffe come gorgonzola, brie, camembert e molti altri;
- Verdura a foglia verde non sufficientemente lavata;
- Germogli crudi;
- Salumi e insaccati crudi.
Come aumentare i globuli bianchi: altri rimedi
Oltre all’alimentazione, per aumentare i leucociti nel sangue si può ricorrere anche ad altre strategie, ad esempio intervenendo sia sullo stile di vita che scegliendo alcuni rimedi naturali. Ovviamente, ogni azione dovrà essere valutata in concerto con il medico. Sia per evitare conseguenze spiacevoli, come possibili effetti collaterali e reazioni allergiche, che per ridurre il rischio di esporsi ad agenti infettivi date le difese naturali ridotte.
Sistema immunitario e stile di vita

Le capacità del sistema immunitario sono innanzitutto influenzate dallo stile di vita. Più si segue un percorso esistenziale sano ed equilibrato, maggiore è la probabilità di affrontare con successo le minacce esterne, riportando le concentrazioni di globuli bianchi a livelli normali. Influiscono positivamente:
- Vitamina C: il consumo di alimenti ricchi di vitamina C – agrumi, kiwi, verdura a foglia verde e molto altro ancora – stimola il midollo osseo a produrre leucociti;
- Attività fisica: mettersi in movimento attiva il sistema immunitario, rafforzandone la protezione. Può essere sufficiente una camminata a passo svelto di trenta minuti ogni giorno per incrementare la produzione di globuli bianchi;
- Riposo: dormire almeno 8 ore al giorno offre maggiori protezioni per l’organismo, poiché l’azione del midollo osseo è più mirata proprio durante il sonno;
- Stress: abbatte la concentrazione di leucociti nel sangue, quindi è necessario ridurne il peso. Sia con l’alimentazione, ad esempio con alimenti ricchi di triptofano quali la lattuga, che ricorrendo a discipline meditative. Fra queste, utili sono lo yoga e il pilates.
Rimedi naturali per i globuli bianchi bassi

Non mancano nemmeno dei rimedi naturali per i globuli bianchi bassi, il cui ricorso va sempre concordato con il medico curante. Fra i più comuni si annoverano:
- Echinacea: rimedio erboristico normalmente scelto per trattare piccoli disturbi da raffreddamento, esprime un’attività mirata proprio a livello di sistema immunitario, stimolando la produzione di anticorpi e globuli bianchi;
- Propoli: un vero e proprio antisettico e antibiotico naturale, prodotto dalle api, disinfetta il cavo orale e con i suoi flavonoidi incentiva l’azione del sistema immunitario;
- Astragalo: ha un’azione immunostimolante per tutto l’organismo, in particolare per i tessuti delle vie respiratorie superiori;
- Rosa canina: uno dei rimedi fitoterapici più ricchi di vitamina C e, pertanto, utile alle difese naturali dell’organismo.
Come già accennato, i rimedi naturali possono determinare effetti collaterali o reazioni allergiche in persone ipersensibili. Ancora, potrebbero non essere compatibili con alcuni trattamenti farmacologici in corso di assunzione: il parere dello specialista rimane quindi imprescindibile.








